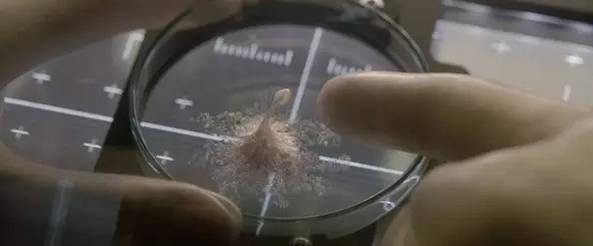

2016年还有十天的时间就要成为过去式了,
今年特别是11月到12月份进口大片儿占了一多半,
公社君今天就来给大家说说2017年将会有哪些重磅大片儿值得你期待。
《乐高大电影:蝙蝠侠》
导 演:克里斯·麦凯
主 演:威尔·阿奈特、迈克尔·塞拉
北美首映日:2月10日

三年不开张,开张吃三年。此前几年华纳推出的动画长片少之又少。
但2014年其联手乐高推出的《乐高大电影》却异军突起,成为当时的票房黑马。
位居2014北美票房榜三甲之列。
豆瓣评分7.9,也非常不错。

这一次,他们继续玩具角色主打模式,
从预告片的风格来看,延续了以往的恶搞。
乐高版蝙蝠侠与传统认知中的蝙蝠侠不同,主打天然呆与反差萌。

而且小丑还出现在本片当中,吐槽蝙蝠侠和超人大战。

而且从海报中可以看出来除了小丑还有小丑女以及杀手鳄等反派身影,
相信这又是一部非常出彩的动画。
《金刚狼:殊死一战》
导 演:詹姆斯·曼高德
主 演:休·杰克曼、达芙妮·基恩
北美首映日:3月3日

休·杰克曼又一次饰演这个角色,据统计这已经是自从2000年的《X战警》休-杰克曼在X战警系列和金刚狼系列累计9次扮演金刚狼,
刷新了同一演员扮演同一漫画英雄角色次数最高的纪录,
而且在漫威英雄里,金刚狼也算是最性感的一个英雄了。

不说别的,就那一身肌肉也足以让人舔屏。
据说,这部片儿也将是金刚狼三部曲的终结篇,也将是休·杰克曼扮演的金刚狼的谢幕之作。

电影的设定是变种人这在渐渐消失,金刚狼和X教授也步入了老年,

本来就打算在一个僻静的地方这样生活下去,但是随着一个小女孩的到来打破了这一切。

她是金刚狼的复制体。
公社君看完预告都要哭了,而且不止公社君一人这样。


因为在这里的金刚狼已经年老,动作也不再那么矫健,身上布满了伤疤。
每次亮过爪子之后,手上都会留下三道长长的疤痕。

英雄老去,是最难过的事,第三部一定是一部情怀之作。
即使这部将是休叔的收官之作,即使他已经指定了下一任的金刚狼,认为他是最好的接班人。
但是我们还是会想那个一言不合就亮爪子的休叔。

《金刚:骷髅岛》
导 演:乔丹·沃格-罗伯茨
主 演:汤姆·希德勒斯顿、布丽·拉尔森
北美首映日:3月10日

作为《金刚》前传的《金刚:骷髅岛》也将于明年上映,
据导演说,这款金刚身高30米,与彼得杰克逊2005年的《金刚》颇为不同,形象上是在致敬1933年的旧版《金刚》。
而且这是金刚将会是影史上最大的一只,将有100英尺(30.48米)高。

这部电影的主演除了你们最爱的抖森,以及去年凭借《房间》斩获奥斯卡最佳女主角的布丽·拉尔森

还有一个,千万不能因为她不看电影,嗯就是最近才毁了一部片儿的景甜。

《美女与野兽》
导 演:比尔·康顿
主 演:爱玛·沃森、 丹·史蒂文斯
北美首映日:3月17日

这部经典的童话翻拍成真人版的,再曝预告片的时候公社君就已经介绍过了,
详情戳→在你渴望王子的时候,我已经在幻想我的野兽了
迪士尼这真的是要将“真人童话片进行到底啊。
最值得说的就是影片将动画还原的程度相当之高。


细节之处做到了这么精细,想必影片本身也应该不错。
《超凡战队》
导 演:迪恩·以色列特
主 演:娜奥米·斯科特、达克雷·蒙特戈梅里 等
北美首映日:3月24日

在超级英雄当道的好莱坞,狮门影业也不能落后,这不就瞄准了1992年播出的日本特摄片《恐龙战队》

后来被美国多次翻拍,风靡一时。
这么经典的IP,应该是引起了很多粉丝的回忆吧,曝光的剧照也是形象的还原了五个战士的样貌。

依旧值得期待的大片儿。
《攻壳机动队》
导 演:鲁伯特·山德斯
主 演:斯嘉丽·约翰逊(少佐草薙素子)、乔汉·菲利普·阿斯(巴特)
北美首映日:3月31日

又是一部日本人气动画之作,从《攻壳机动队》真人电影启动的那一刻起,
该片进展的一举一动都备受业界和动漫爱好者的关注。
因为它是公认的神作,日本动画无可逾越的高峰。
特别是电影的主演是寡姐,这就更让人期待了。

虽然原作中的草薙素子,是东方人。
但从预告剧照来看,寡姐真的是毫无违和感。
据说本来主演定的是饰演小丑女的玛格特·罗比,但是因为档期的缘故,她选择了《自杀小队》。

从预告片来看,这部真人版的《攻壳机动队》虽然不能说十分完美的还原了动画,
但至少尽可能的还原了动画中的一些经典场景和设定,
并且还将一些动画中展现不足的信息重新呈现出来了。

对于这部片儿,公社君表示非常期待。
《速度与激情8》
导 演:F·加里·格雷
主 演:范·迪塞尔、道恩·强森、杰森·斯坦森
北美首映日:4月14日

去年的《速度与激情7》在内地收获20亿,票房高的惊人,
不可否认的是这部作品大家都是冲着纪念保罗沃克去的。
结尾的那首see you again也唱哭了每一个到场观众的心。

虽然故事越来越套路,但大家依旧买账,不过速激系列最出彩的想必一定是第五部了。

明年的第八部也有望同步引进。
《速7》的结局中,保罗也选择了离开这个大家庭,似乎也是为奥康纳这个角色安排了一个很好的结局。
但是在速8开拍之前就有小道消息说会继续加入保罗的戏份,至于是怎样的还未知。等上映了自然就揭晓答案了。
《银河护卫队2》
导 演:詹姆斯·古恩
主 演:克里斯·帕拉特(星爵)、佐伊·索尔达娜(卡魔拉)
北美首映日:5月5日

这部片儿算是公社君最爱的一部漫威系列的电影了,
比起苦大仇深的复仇者联盟,这支英雄战队走的完全不是一个戏路。

每年北美暑期档打头炮的多是漫威系的超级英雄片,今年也不例外。
将《银河护卫队2》的档期提到如此显赫的位置上,足见迪士尼漫威对本片的倚重。
第二部中最吸引人的就是小树人格鲁特的出现,
在第一部中,格鲁特最后为了自己的队友而牺牲,好在浣熊保留了他的根,让他得以存活下去。

而小树人在这一部当中负责搞笑以及卖萌担当。

第二部将围绕着星爵的身世展开,银护的所有成员一一亮相,
这群人的扮相、服饰,甚至是口头禅都与前作并无二致。

绝对是年度非常值得期待的漫威系列的电影之一。
《加勒比海盗5》
导 演:乔阿吉姆·罗恩尼
主 演:约翰尼·德普、哈维尔·巴登、卡雅·斯考达里奥
北美首映日:5月26日

时隔六年,加勒比海盗终于迎来了第五部曲,
一路走来非常不易,继第四部上映后的口碑不佳,导致这一部这么晚才能和观众见面。
德普也终于又一次穿上了那身让人过目不忘的海盗服。

自拍完《海盗4》之后,德普的人气持续下滑,参演的影片大都反响平平,甚至各种负面新闻不停。
这一次相信德普的回归一定是卯足了劲儿。
除了德普之外,杰弗里·拉什饰演的巴博萨船长和精灵王子奥兰多·布鲁姆饰演的威尔也将回归。

预告片以阴森海域和大雾缭绕的山峰开启,烘托出惊悚氛围。

哈维尔·巴登扮演的大反派布兰德船长霸气登场,
他手中的利刃肆意斩杀船员,但最终目的还是找到威尔和伊丽莎白的儿子亨利(布兰顿·思怀兹 饰)。

找到亨利后,面目狰狞的布兰德船长挑起地上印有杰克·斯帕罗画像的通缉令,要求亨利替他找到杰克船长,并威胁道:“死神要找上门了。”
《异星觉醒》
导 演:丹尼尔·伊斯皮诺萨
主 演:杰克·吉伦哈尔、丽贝卡·弗格森
北美首映日:5月26日

这部片儿就冲着主演,公社君不看片儿都要5星送上,没错就是杰克·吉伦哈尔,

曾主演过《断背山》、《源代码》以及今年《铁拳》的他,
是一个为了演戏可以豁出性命的人。
公社君之前也写过一篇关于他的文章,感兴趣戳好莱坞欠他的不止一座小金人
另一外主角曾主演《死侍》的瑞安·雷诺兹;

作为索尼的年度科幻大片儿,从演员到制作都是一流的水准,
故事的背景,发生在外太空,杰克和死侍,(暂且这么叫吧)在外太空带回了一个样本,经检测发现有生命迹象。
本来很高兴的他们,却被人警告这种生物如果带到地球,将会有毁灭性的威胁。
话说,杰克和瑞恩一个人就可以撑起一部片儿了,这部片儿竟然还奢侈的用了两个。
《神奇女侠》
导 演:派蒂·杰金斯
主演:盖尔·加朵、克里斯·派恩
首映日:6月2日

公社君女神主演的漫威英雄大片儿能不好看吗,从速度与激情的时候就被盖尔加朵迷的不要不要的。
之后蝙蝠侠大战超人中,公社君的关注点不是不是特效也不是两个老男人打架,而是神奇女侠的惊艳出场。

今年的《邻家大间谍》女神那身材真的是啥也不想说了,舔屏就够了。

当然除了颜值,还有演技,戳抛开别的不说,光是她的腿就足以让人血脉喷张
咳咳,公社君忘了自己是来写稿的,不是来犯花痴的。
故事的背景设定在上个世纪二十年代,盖尔加朵生长在一个美丽的小镇上。
因为她的家人被卷入战争,于是她曾想拯救世界。

最终她挥起了武器,为人类而战。
总之,不管说什么,公社君都一定会去看的。
《变形金刚5》
导 演:迈克尔·贝
主演:马克·沃尔伯格、彼特·库伦(配音:擎天柱)
北美首映日:6月23日

作为人见人爱花见花开的变形金刚系列在明年将推出第五部,
变形金刚系列也真的算是一部神奇之作了,口碑一部比一部差,票房却一部比一部高。
这都要归功于导演,迈克尔·贝 。
导演也多次发声说“再也不拍变形金刚了”然而一次又一次的打脸。

不过这一次导演又一次发声了“保证这是最后一次执导了”

这一次应该是真的了,毕竟《变形金刚6》将在2018年暑期上映,
所以导演在分身乏术的情况下是不可能再去戕害变形金刚了。
希望这一部不会烂。
《神偷奶爸3》
导 演:凯尔·巴尔达
配 音:达娜·盖伊(埃迪丝)、皮埃尔·柯芬(小黄人)、史蒂夫·卡瑞尔(格鲁)
北美首映日:6月30日

之前曝预告片的时候公社君就说过了,这群萌贱萌贱的小黄人又来闹事了,

从预告片来看,还是延续了之前的风格,
不过本次的反派还真是有点不一样,一言不合就尬舞。

前两部的评分都很高。

相信第三部不出意外的话,依旧是一部非常值得期待的系列之一。
《蜘蛛侠:归来》
导 演:乔·沃茨
主 演:汤姆·赫兰德玛丽莎·托梅
首映日:6月30日

看漫威的电影久了你会发现,无论是复仇者联盟阵营,还是当所有英雄都聚在一起,
总是缺少了那个贱兮兮的蜘蛛侠。
这是因为早前漫威把这个人物的版权卖给了索尼。
而去年漫威与索尼合作后,才有了《复仇者联盟2》中蜘蛛侠的登场。

之前索尼拍的两版蜘蛛侠,都不是同一个演员,
一个是公社君爱的安德鲁·加菲尔德。

另一个是托比·马奎尔。

而这一次主演又换了,就是在复联2中出现的最小蜘蛛侠汤姆·霍兰德。

虽然年纪小,但是不用担心,因为唐尼会来助阵。

超期期待啊,有木有。
《猩球崛起:终极之战》
导 演:马特·里夫斯
主 演:安迪·瑟金斯(动作捕捉)、朱迪·格雷尔
北美首映日:7月14日

猩球系列从2011年第一部开始,口碑就非常不错,
同样是拍猩猩,本片中的凯撒充分展示了猩猩的智慧,
而2017年的这一部将成为“猩球”系列的终级章。
最值得说的是凯撒的演员安迪·瑟金斯,
公社君最服演猴子的两个人,一个是我们的六小龄童,另一个就是他。


简直是神还原,奥斯卡真的就欠他一座小金人。

《敦克尔刻》
导 演:克里斯托弗·诺兰
主 演:汤姆·哈迪、肯尼思·布拉纳
北美首映日:7月21日

这是一部凭借导演大名就能满分送上的片子,没错就是克里斯托弗·诺兰。

而且这一次诺兰的这部片儿不是翻拍、不是续集、不是外番,而是原创。
电影围绕着二战时期著名的敦刻尔克大撤退展开。

自从2014年的一部电影《星际穿越》之后诺兰便一直没有动静。
而之后的这段时间诺兰都是在为这部电影做准备。

所以对于这部电影公社君也是非!常!期!待!
《异形 契约》
导 演:雷德利·斯科特
主演:迈克尔·法斯宾德、劳米·拉佩斯
北美首映日:8月04日

首先导演雷德利斯科特,就是质量保证。
作为怪兽片的经典之作,异形系列目前分成了两个电影系列,
一个是讲述接着第二部讲故事的《异形5》,预计2020年上映。
另一个是作为前传的普罗米修斯系列,也就是《异形 契约》。
在这一部作品中据说导演会加强惊悚元素,而且这部《异形》会比《普罗米修斯》更恐怖,

但还是会和《普罗米修斯》大体上保持一致。
只不过会更有《异形》里那种惊悚、灾难迫近的感觉。
而法鲨也将继续在本片中扮演生化人的角色。

《雷神3:诸神黄昏》
导 演:塔伊加·维迪提
主 演:克里斯·海姆斯沃斯、马克·鲁法洛
北美首映日:11月03日

同样是作为雷神三部曲中的最后一部,
不仅有锤哥以及抖森的回归,还有安东尼·霍普金斯饰演的老国王奥丁。

而且雷神与马克·鲁法洛饰演的绿巨人的PK也是本片的一大看点。
看来明年漫威真的是非常忙碌的一年啊。
《正义联盟》
导 演:扎克·施奈德
主 演:亨利·卡维尔、本·阿弗莱克、盖尔·加朵 等
北美首映日:11月17日

明年可谓华纳及DC基于漫改超级英雄影片的关键一役,漫威有复仇者联盟,DC有正义两联盟,

如果说DC的《神奇女侠》无法左右大局的话,
那么年底的《正义联盟》可谓是下了所有的赌注。
本·阿弗莱克饰演蝙蝠侠;盖尔·加朵饰演神奇女侠;亨利·卡维尔饰演超人。
还有闪电侠、绿箭侠、绿灯侠、水人等等。

希望这会是DC的一部经典大作。
《星球大战8》
导 演:莱恩·约翰逊
主 演:黛茜·雷德利、约翰·波耶加
北美首映日:12月15日

星战系列算是好莱坞超强的一个IP了,
看到迪士尼将《星球大战8》放在年末,就知道这部片儿的重量所在。
而这部的内容将会紧呈第七部的故事,至于本片的卡司那自然不用多说。

说了这么多,真的是每一部都不容错过啊,
不能再说下去了,钱包已经不允许了,
新的一年公社君的目标就是赚钱看大片儿!
纵贯电影公社独家文章,未经允许请勿转载


评论